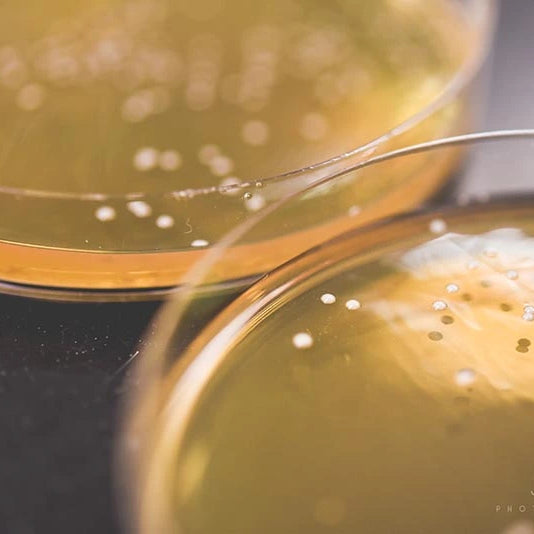

PLUS QU'UNE SIMPLE ENTREPRISE
Notre entreprise, fondée en 2015, se dédie à la fabrication de ferments liquides de première qualité. Nous sommes d’ailleurs le premier producteur de ferments dédiés à la production de bière au Québec. Depuis 2025, l'équipe du Labo a fusionné avec celle d'Escarpment Labs, en plus d'être désormais distributeur officiel de levures sèches de Lallemand Brewing.
Comme on le dit souvent, « Brassons les idées avant la bière !».
FOURNISSEURS DE FERMENTS ET ENCORE PLUS
Pour nos clients, travailler avec Le Labo, c’est avoir accès à une équipe de passionnés aguerris qui travaillent en fonction de vos contraintes.
Nos services de consultation, de développement de ferments et de formation sur mesure ont permis à des dizaines de brasseries d’optimiser leur procédé, d’améliorer la qualité de leurs produits et de développer des bières uniques.
Le Labo - Solutions Brassicoles, un partenaire de premier choix de l'industrie !
LA QUALITÉ AVANT TOUT
Depuis sa fondation, les acteurs du Labo se sont donnés comme mission de mettre la qualité au premier plan.
C’est sans compromis que cette valeur phare nous guide dans l’ensemble de nos activités et nous permet de satisfaire les consommateurs les plus exigeants. Que ce soit par une gestion stricte de la qualité de nos ferments ou par le professionnalisme de nos consultants, nous vous offrons le meilleur de la science brassicole.
Soyez sans crainte d'obtenir vos ferments à la hauteur de vos attentes.
NOTRE RESPONSABILITÉ SOCIALE ET ENVIRONNEMENTALE
Pour que notre entreprise exerce une influence positive sur son milieu et son environnement,
nous avons adopté les orientations suivantes :
- Appliquer les principes de l’économie circulaire et du développement durable et valoriser les produits issus de notre production.
- Porter une attention particulière à la qualité de notre milieu de travail et au bien-être de nos collègues.
COLLABORATION ET PARTAGE
La collaboration et le partage avec les brasseurs et partenaires de l’industrie font partie intégrante de nos valeurs.
Notre esprit collectif se traduit, notamment, par:
- Un support financier aux activités éducatives.
- Notre participation à des projets de brassage collaboratifs.
- Une implication soutenue lors des évènements de l’AMBQ et du MBAA.
- Une diffusion des connaissances scientifiques développées lors de nos projets de recherche.